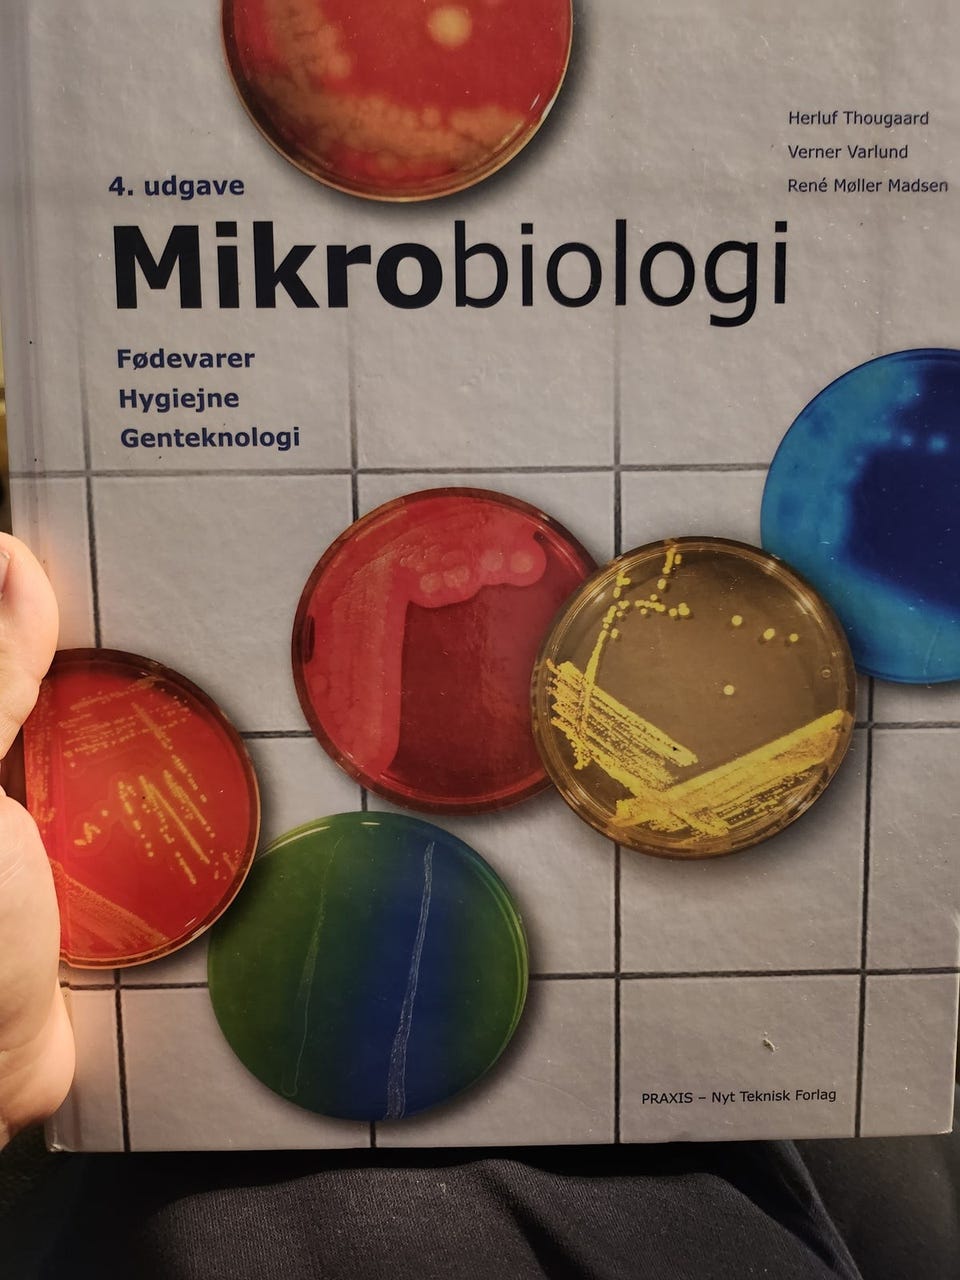
Galleribillede

Billedgalleri
(1/1)
Mikrobiologi 4 udgave, Herluf Thougaard, emne: biologi og botanik
Til salg
Fiks færdig
145 kr.
Fragt fra 29,99 kr. + Tryg betaling 14 kr.
Tryg handel med Fiks færdig
Fiks færdig er DBA's nye betalings- og fragttjeneste. Efter levering har du 24 timer til at kontrollere varen, før pengene udbetales til sælgeren.
Varebeskrivelse
Emne: Biologi
Mikrobiologi 4 udgave, Herluf Thougaard, emne: biologi og botanik, 1
Bemærk: Knappen til at vise den fulde beskrivelse har kun en visuel effekt.
Brugerprofil
Du skal være logget ind for at se brugerprofiler og sende beskeder.
Log indAnnoncens metadata
Sidst redigeret: 14.12.2024 kl. 15:59 ・ Annonce-ID: 2009468